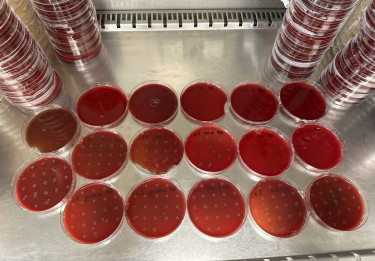

Key to our research over the past 20 years is the anaerobic Gram-positive enteropathogen Clostridioides difficile. Motivated by epidemiological and diagnostic challenges in the early 2000's during outbreaks of C. difficile, our work has since then expanded into other, more fundamental, aspects as well. Some of our favorite topics include antimicrobials and antimicrobial resistance, stress responses, plasmids, proteolysis, post-translational modifications, and DNA replication.
In addition to C. difficile, we also work on other organisms, such as Staphylococcus aureus, Enterococcus faecium, Pseudomonas aeruginosa, Escherichia coli and Ruminococcus gnavus, for instance. We have a particular interest in differences and similarities between C. difficile and these other organisms, and how organisms interact in the context of complex communities, such as the gut microbiome.
Most recently, we have been developing controlled human colonization and infection models for C. difficile.
Techniques
Our lab employs a variety of techniques, including (anaerobic) bacterial culture and phenotypic assays (spore formation, toxin production, resistance to stressors and antimicrobial drugs). Our labs are equipped to perform genetics experiments. A major part of our activities involves work with (heterologously) purified proteins for use in biochemical and biophysical assays. Complex omics experiments and structure determination by cryo-electron microscopy or X-ray crystallography are conducted in collaboration with experts. We routinely perform whole genome sequence analysis for both diagnostics and research.
Our lab employs a variety of techniques, including (anaerobic) bacterial culture and phenotypic assays (spore formation, toxin production, resistance to stressors and antimicrobial drugs). Our labs are equipped to perform genetics experiments. A major part of our activities involves work with (heterologously) purified proteins for use in biochemical and biophysical assays. Complex omics experiments and structure determination by cryo-electron microscopy or X-ray crystallography are conducted in collaboration with experts. We routinely perform whole genome sequence analysis for both diagnostics and research.


